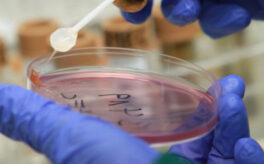

Новини

Уголь из ЮАР прибыл в порт «Южный» (видео)
7 Грудня 2015, 15:10
В Одессе отметили День Вооруженных сил Украины (видео)
7 Грудня 2015, 14:51
Прямое включение Приморский районый суд г. Одессы (видео)
7 Грудня 2015, 14:35
Новое “Слово Дня” в Утре на 7. А вы знаете, что такое экивоки?
7 Грудня 2015, 14:34
Очередное ложное минирование в Приморском районном суде Одессы (фото)
7 Грудня 2015, 13:55
7 декабря: Новости. Сегодня в мире (выпуск от 13:00)
7 Грудня 2015, 13:35
7 декабря: Новости. Сегодня в мире (выпуск от 12:00)
7 Грудня 2015, 12:34
Одесситка завоевала “золото” чемпионата мира по степу
7 Грудня 2015, 12:28
Задержаны и отменены несколько рейсов из-за утреннего тумана в Одесском аэропорту
7 Грудня 2015, 11:33
Ночью произошел пожар в одном из одесских кафе
7 Грудня 2015, 10:44
«Утро на 7». Элина Розина
7 Грудня 2015, 10:20
В порт “Южный” привезли более 150 тыс тонн африканского угля (фото)
7 Грудня 2015, 09:55
Острую кишечную инфекцию обнаружили у пятерых детей в Ильичевском детсаду
7 Грудня 2015, 09:09
Завершается реставрация здания, в котором расположен Всемирный клуб одесситов
7 Грудня 2015, 08:27
«Вечер на 7». Соломия Бобровская
6 Грудня 2015, 22:00
«Вечер на 7». Олег Гуляк
6 Грудня 2015, 21:00Інші Категорії
7 канал production
7я
COVID-19
Free talk
Kyiv Post Review
Live Studio
В регіоні
Важливо на 7
Великі
Відео news 7
Власна думка
Гості «Ранку на 7»
Грань
Еconomic news review
Зарядка на 7
Золота середина
Історії із зоопарку
Ключові моменти
Крик душі
Маленькі подорожі
На вартi
Надбання Одеси
Новини
Нормально
О спорт
Підсумки тижня
Політика. Бізнес. Економіка.
Порада дитячого психолога
Порада лікаря
Програми
Прожектор v 2.0
Ранок на 7
Світло на 7
Серце, віддане людям
Сніданок на 7
Солов'їна
Соціальні експерименти
Соціальні проекти
Спецрепортаж
Спочатку було слово
Сьогодні у світі
Твоя конституція
Топ дня
Чорне дзеркало

